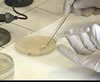

| Kirby Bauer Testi |

Kirby Bauer Testi |
| Disk dif�zyon testi. Kimyasal ila�larla yap�lan tedavilere mikroplar�n duyarl�l���n� tayin etmek i�in kullan�lan bir agar dif�zyon testi. |
| Kirby Bauer Testi |
Kirby Bauer Testi |
| Disk dif�zyon testi. Kimyasal ila�larla yap�lan tedavilere mikroplar�n duyarl�l���n� tayin etmek i�in kullan�lan bir agar dif�zyon testi. |